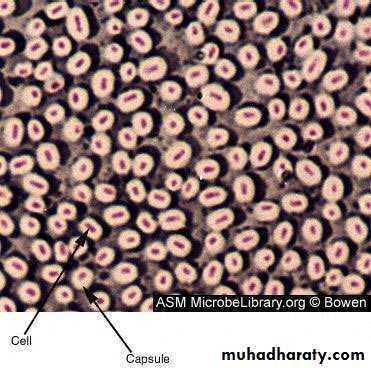

Lab.7:- Capsule Stain
Ph.D. Lecturer MSc. Teacher Assistant Zubiada Najat Mustafa Noor Mahmood ShakoorGLYCOCALYX
GLYCOCALYX is the term used to refer to all polysaccharide-containing substances found external to the cell wall, from the thickest capsules to the thinnest slime layers. Most bacteria have at least a thin slime layer.A capsule is a protective structure outside the cell wall of the organism that secretes it. The cell that posses the capsule are called as capsulated cell and those who lack the capsule are called as the non-capsulated bacteria.
A slime layer is less tightly bound to the cell wall and is usually thinner than a capsule. When present, it protects the cell against drying, helps trap nutrients near the cell, and sometimes binds cells together as in dental plaque.
Chemical composition of capsule:-
Chemically, the capsular material is synthesize by large amounts of extracellular polymer when growing in their natural environments :-Polysaccharides e.g. Streptococcus pneumoniae .
Polypeptide (Poly-D-glutamic acid) e.g. Bacillus anthracis.
Capsule is mainly of two types
Micro-capsule – Its size is less than 0.2 µm.
Macro-capsule – Its size is more than 0.2 µm.
PRINCIPLE
Capsule staining is more difficult than other types of differential staining procedures because the capsular materials are water soluble and may be dislodge and removed with vigorous washing.
Bacterial smears should NOT be heated, are destroyed by heat-fixing, so this step is omitted and these microbes are affixed to the slide just by air-drying.
PRINCIPLE
Basic dyes cationic (positively charged) .These dyes are attracted to any negatively charged cell components. The cell membranes of most bacteria have negatively charged surfaces and thus attract the positively charged basic dyes.Other stains, are acidic dyes anionic (negatively charged), They are attracted to any positively charged cell materials.
The capsule is non-ionic, so that the dyes commonly used will not bind to any stain.
Function of capsule
Protect the cell from phacocytosis.To protect the cell from desication.
To protect the cell from harmful environmental conditions.
Protection of anaerobes from oxygen toxicity.
A virulence determinant of pathogenic microbes. E.g. Streptococcus pneumoniae.
It also aids bacterial attachment to surfaces of solid objects or to tissue surfaces.
Capsule staining can be done in two ways they are
Positive staining method (Hiss Staining method).
Negative staining method (Maneval’s method).
Hiss Staining method – Positive staining method
AimTo stain the capsule of bacterial cell by Hiss method.
Requirements
36–48 hour culture of Klebsiella pneumonia capsulated cell culture.
1 % Crystal violet, and 20 % Copper sulfate.
Procedure
1.A smear is prepared on a clean grease free slide.
2.The smear should not be heat fix it should be just air dried.
3.After air drying the smear is flooded with 1% Crystal violet for about 4 – 5 minutes.
4.After 5 minutes the smear is rinse with 20% copper sulfate solution.
5.The slide is air dried and observed under oil immersion objective.
Negative staining method
Materials:
36–48 hour culture of Klebsiella pneumonia, india ink, crystal violet.
1.Place a small drop of a negative stain(Indin Ink) on the slide.
• 2.Using sterile technique, add a loopful of bacterial culture to slide, smearing it in the dye.
• 3.With an other slide, drag the ink-cell mixture into a thin film along the first slide and let stand for5-7 minutes.
• 4.Allow to air dry (do not heat fix), just air dried.
• 5.Flood the smear with crystal violet stain (this will stain the cells but not the capsules) for about 1 minutes.
• 6.Drain the crystal violet by tilting the slide at a 45 degree angle and let stain run off until it air dries .
7.Examine the smear microscopically (100X) for the presence of encapsulated cells as indicated by clear zones surrounding the cells